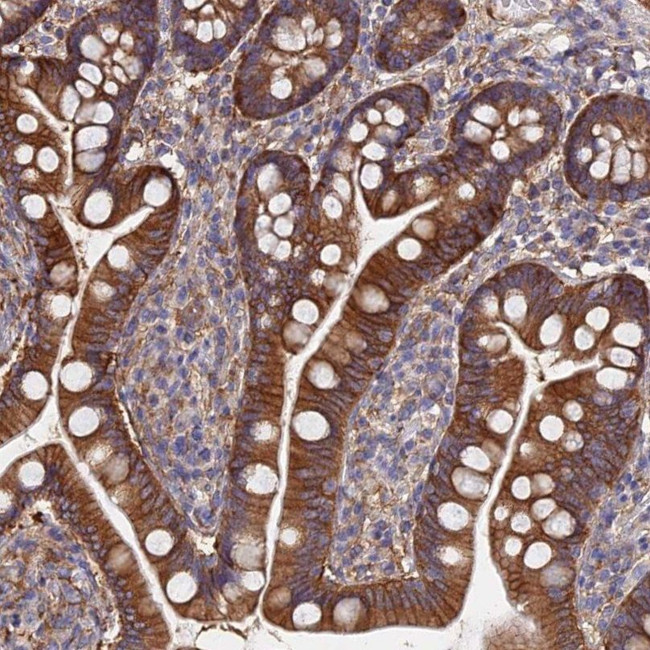
GPR41 Antibody in Immunohistochemistry (IHC)

Search
Invitrogen
GPR41 Polyclonal Antibody
{{$productOrderCtrl.translations['antibody.pdp.commerceCard.promotion.promotions']}}
{{$productOrderCtrl.translations['antibody.pdp.commerceCard.promotion.viewpromo']}}
{{$productOrderCtrl.translations['antibody.pdp.commerceCard.promotion.promocode']}}: {{promo.promoCode}} {{promo.promoTitle}} {{promo.promoDescription}}. {{$productOrderCtrl.translations['antibody.pdp.commerceCard.promotion.learnmore']}}
产品信息
PA5-60791
种属反应
宿主/亚型
分类
类型
抗原
偶联物
形式
浓度
规格
纯化类型
保存液
内含物
保存条件
运输条件
RRID
产品详细信息
Immunogen sequence: DFHELLRRLC GLWGQWQQES SMELKEQKGG EEQRADRPAE RKTSEHSQGC GTGGQVAC
Highest antigen sequence identity to the following orthologs: Mouse - 32%, Rat - 33%.
靶标信息
G protein-coupled receptors (GPRs), also known as seven transmembrane receptors, heptahelical receptors or 7TM receptors, comprise a superfamily of proteins that play a role in many different stimulus-response pathways. GPRs translate extracellular signals into intracellular signals (a process called G-protein activation) and they respond to a variety of signaling molecules, such as hormones and neurotransmitters. GPR41 (G-protein coupled receptor 41), also known as FFAR3 (Free fatty acid receptor 3), is a 346 amino acid multi-pass membrane protein that belongs to the G protein-coupled receptor family. Expressed at high levels in adipose tissue and at lower levels throughout the body, GPR41 functions as a receptor for short chain fatty acids via elevation of intracellular calcium levels and inhibition of adenylyl cyclase.
仅用于科研。不用于诊断过程。未经明确授权不得转售。
篇参考文献 (0)
生物信息学
蛋白别名: Free fatty acid receptor 3; G-protein coupled receptor 41; Gpcr41; unnamed protein product
基因别名: FFA3R; FFAR3; GPR41; GPR42
UniProt ID: (Human) O14843
Entrez Gene ID: (Human) 2865